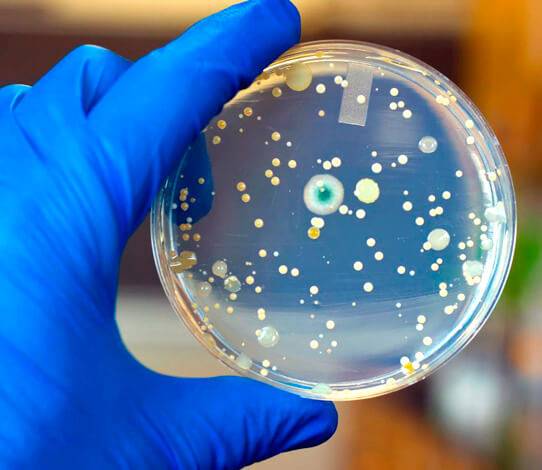

Как отличить
Для того чтобы понять, как отличить ангину бактериальную от вирусной, необходимо внимательно присмотреться к симптомам обеих, так как именно там кроется их основное отличие.
Итак, первым отличием является отсутствие белого налета на миндалинах при вирусном варианте болезни. Не увеличиваются в этом случае и лимфоузлы.
Нет при вирусной ангине и четкой локализации воспаления. Если при бактериальном заболевании первыми страдают гланды, то при вирусном воспаляется все горло.
Как правило, вирусная болезнь характеризуется и постепенным началом: боль в горле сначала периодическая, начинает беспокоить все чаще, при этом повышается температура тела и проявляется воспаление.
Бактериальная же начинается резко – одновременно краснеет горло, на гландах появляется налет и наблюдается быстрое повышение температуры.
Еще одно характерное отличие вирусной ангины от бактериальной заключается в том, что она может сопровождаться ринитом, так как вирус «захватывает» не только горло, но и носоглотку. Подобный симптом при бактериальной ангине отсутствует.
Что касается кашля, то он может проявляться и в том, и в другом случае. Но симптом будет разным. Если причина болезни горла – бактерии, то кашель появляется как симптом при осложнении из-за ненадлежащего лечения. В этом случае кашель сухой, его приступы могут вызывать боль не только в горле, но и в груди.

Помимо насморка и кашля у больного при вирусной форме тонзиллита может наблюдаться и слезотечение. В этом случае возбудителем, скорее всего, является риновирус.
В целом, при вирусной ангине заболевание протекает в более легкой форме, и температура тела больного обычно не повышается больше 38°С. После острой стадии наступает облегчение, в то время как у болезни, вызванной бактериями, наблюдается стабильное течение.
Помимо основных симптомов при ангине, спровоцированной вирусом герпеса, могут наблюдаться высыпания, боли в животе, расстройство желудка.
Знания того, чем отличается бактериальная ангина от вирусной, несомненно, будут полезны каждому, особенно если в семье подрастают дети.
Однако пытаясь самостоятельно разобраться в нюансах заболеваний, поставить себе диагноз и начать лечение, можно упустить время. А ведь время может играть решающую роль в развитии и лечении бактериальной разновидности тонзиллита.
различия в клинических проявлениях
Надежнее всего отличить вирусную ангину от бактериальной можно, изучив результаты анализов крови и бакпосева из горла. По ним можно определить наличие или отсутствие в мазке из глотки, собственно, бактерий
Важно здесь то, что такие анализы можно смело сдавать и ждать результата, не опасаясь, что будет упущено время. Дело в том, что при вирусной инфекции никакого специфического лечения не требуется вовсе, а при ангине 3-4 дня, достаточные для получения результатов анализа, не повлияют на безопасность и эффективность применения антибиотиков
При вирусном поражении глотки после бакпосева в чашке Петри не высевается какой-либо возбудитель в патогенных количествах. Сама культура при этом выглядит как набор многих условно-патогенных штаммов бактерий.
Полупрофессиональное отличие вирусной ангины от бактериальной можно провести в домашних условиях с помощью специального экспресс-теста на стрептококк. Такие тесты сегодня продаются в аптеках. Здесь в специальный раствор опускается тампон с мазком из глотки, а затем по окраске индикатора на специальной полоске можно определить, присутствует ли в мазке стрептококк (а значит, имеет место бактериальная инфекция), или нет (то есть речь идет о вирусном заболевании). Технически это похоже на использование теста на беременность.

Алгоритм использования стрептотеста: 1. В пробирку наливается 4 капли жидкости из красного флакона; 2. В неё же добавляется 4 капли жидкости из желтого флакона; 3. Содержимое пробирки тщательно перемешивается и оставляется на 1 минуту; 4. С миндалин у больного ватным тампоном на конце палочки снимается порция слизи; 5. Тампон опускается в пробирку, а затем отжимается в неё же; 6. На 5 минут в пробирку опускается тест-полоска.
При этом положительный результат теста и наличие стрептококка означает бактериальную природу ангины, но его отсутствие не является гарантией того, что ангина именно вирусная. Тест не чувствителен к стафилококкам, гонококкам и веретенообразным палочкам, которые также могут вызывать ангину.
Важно помнить, что все визуальные признаки не позволяют определить, вирусная ангина у больного, или бактериальная, с достаточной надежностью:
- В случаях с кашлем и насморком бывают исключения;
- Гной является неоднозначным признаком и позволяет диагностировать только фолликулярную ангину или хронический тонзиллит;
- Экспресс тесты на стрептококк не исключают наличие стафилококка, как возбудителя болезни.
То есть для надежной диагностики причины болей в горле необходимо обратиться к врачу, который сможет оценить все признаки в комплексе, а при необходимости — возьмет разные материалы больного на анализ. При самостоятельной диагностике в домашних условиях очень легко ошибиться, а затем начать неправильное лечение, что окончится тяжелыми осложнениями.
Однозначно визит к врачу точно необходим, если у больного болит горло, но нет насморка. Это признак или бактериальной ангины, или гриппа, и обе эти болезни требуют контроля у специалиста. Также врача нужно обязательно посетить при появлении гноя или гноеподобного налета на миндалинах.

При любых серьезных болях в горле и развитии недомогания нужно показаться врачу. Болезнь может быть более опасной, чем предполагает больной или его родители!
Резюме
- Если при боли в горле имеются насморк и кашель (либо что-то одно из них), то речь скорее всего идет о вирусной инфекции. При ангине ни насморк, ни кашель не развиваются;
- Если на миндалинах образуются аккуратные четкие белые гнойнички, это скорее всего бактериальная фолликулярная ангина;
- Если гной или другие поражения распространяются на мягкое небо или вглубь горла, это с большой вероятностью вирусная или грибковая инфекция;
- Определить тип заболевания в домашних условиях без медицинской подготовки крайне сложно. Для точной диагностики следует обращаться к врачу.
Видео: Доктор Комаровский рассказывает, как можно отличить вирусную болезнь от ангины
Как можно отличить герпесную ангину от бактериальной?
Может ли ребенок не чувствовать боль при вирусной ангине?
Что делать, если больная саркоидозом заболела вирусной ангиной?
Какой бывает ангина?
Воспаление при ангине может протекать по-разному: поверхностно или глубоко, со склонностью к разрушению ткани или без1,4. Говоря о глубине воспаления, уточняют, какие анатомические структуры поражены5,7. Если посмотреть на свободную поверхность миндалин, можно заметить, что она неровная и имеет углубления — лакуны7. Вдоль лакун расположены фолликулы, они представляют собой скопления иммунных клеток в виде мешочков7. Мешочки не видны, но, воспаляясь, становятся заметными1. Зная эти особенности, врачи выделяют несколько видов ангин1,5.
Катаральная
Простое воспаление, при котором осложнений не бывает. Воспаляется только слизистая оболочка миндалин, они краснеют и отекают. Температура тела повышается незначительно, ощущается дискомфорт в суставах, мышцах, беспокоит головная боль, при глотании болит горло1,5.
Лакунарная
Воспаление проникает глубже, в лакуны. При осмотре миндалины опухшие, ярко-красные, покрыты гнойным налетом — белого или серого цвета1,5. Появляются симптомы интоксикации — сильная головная, мышечная, суставная боль, температура повышается до 39 °C1,5.
Фолликулярная
Развивается как осложнение предыдущей формы, если инфекция проникает в фолликулы. Все симптомы ангины очень выражены, нагноившиеся фолликулы видны как беловато-желтые точки1,5. Без лечения возможны разные осложнения1.
Осложненная ангина развивается не сразу: она переходит от самой простой, катаральной, до лакунарной и фолликулярной1,5
Чтобы предупредить развитие более тяжелых форм, очень важно своевременно обратиться к врачу и начать лечение1
Важные отличия тонзиллита и ОРВИ
У вирусной инфекции и тонзиллита есть схожие начальные симптомы, из-за которых эти заболевания часто путают. Они включают:
- Повышение температуры тела (внезапное или постепенное);
- Воспаление слизистой оболочки горла;
- Общие симптомы интоксикации организма (слабость, вялость, боль в суставах).
Не следует сразу ставить самостоятельно диагноз и принимать лекарства. Если нет уверенности, лучше вызвать врача на дом или обратиться на прием.
Несмотря на схожесть клинической картины, ангина существенно отличается от других ЛОР-патологий. Она обычно начинается резко, без предварительных признаков, с поднятия температуры до высоких значений и сильной боли в горле при глотании. Отек миндалин и наличие казеозных пробок также являются важными отличительными признаками острого тонзиллита.
Для точного отличия ангины от других простудных заболеваний необходимо обращать внимание на клинические проявления. Как отличить грипп от ангины? Грипп сопровождается яркими респираторными симптомами, такими как насморк, чихание, заложенность носоглотки и покраснение слизистой горла
Влажный кашель также характерен для гриппа. В то время как ангина не сопровождается заложенностью носа и чиханием, а кашель может быть сухим на фоне болезненного горла
Как отличить грипп от ангины? Грипп сопровождается яркими респираторными симптомами, такими как насморк, чихание, заложенность носоглотки и покраснение слизистой горла. Влажный кашель также характерен для гриппа. В то время как ангина не сопровождается заложенностью носа и чиханием, а кашель может быть сухим на фоне болезненного горла.
Как отличить ангину от гриппа по температурным показателям? Это сложно, так как оба заболевания могут сопровождаться высокой температурой, особенно у детей. Однако есть одно отличие: при ангине температура снижается сразу после начала приема антибиотиков, в то время как при гриппе антибактериальные препараты только ухудшат состояние. Поэтому различить эти заболевания можно по комплексу симптомов.
Простуда обычно протекает легко и без сильного дискомфорта. Человек часто продолжает свою повседневную жизнь. В то время как тонзиллит вызывает сильную боль и плохое самочувствие. Больной не может ни есть, ни глотать слюну.
Ангину также можно определить визуально. Если видны опухшие миндалины с гнойными пробками, то это скорее всего ангина. При фарингите и ларингите задняя стенка гортани и небные дуги воспаляются, но налета нет.
Лечение болезни зависит от правильного диагноза. Противовирусные препараты не помогут при ангине, так же как и антибиотики при ОРВИ. Инфекции, вызванные вирусами, требуют симптоматической терапии, такой как полоскания травами и аптечными растворами, орошение горла спреями, рассасывание леденцов и ингаляции небулайзером. Это помогает организму бороться с вирусом и восстанавливаться самостоятельно. Грипп иногда требует противовирусной терапии, иногда в стационарных условиях.
Антибактериальные препараты необходимы для лечения острого тонзиллита. Только они могут уничтожить бактериальную инфекцию и очистить миндалины от налета. Аугментин, Азитромицин, Амоксиклав и Сумамед являются эффективными против стрептококков и стафилококков. Полоскания, орошения и теплое питье помогают облегчить боль и воспаление в горле, но не вылечат болезнь.
Назначение антибиотиков должно осуществляться только врачом, самостоятельный прием препаратов этой группы может привести к серьезным осложнениям.
ОРВИ обычно проходит без специального лечения, в то время как ангина требует комплексного медикаментозного подхода.
Ангина может привести к осложнениям, которые могут возникнуть сразу после выздоровления или через несколько месяцев. Нелеченный тонзиллит или неправильный выбор препаратов могут привести к серьезным последствиям, таким как сердечная недостаточность, патология почек, ревматизм и абсцесс. Осложнения ангины иногда могут привести к инвалидизации.
ОРВИ обычно заканчивается полным выздоровлением. В некоторых случаях может развиться бронхит или пневмония, но они обычно успешно лечатся в амбулаторных условиях.
Своевременная диагностика и лечение всех простудных заболеваний могут предотвратить неприятные последствия.
Лечение ангины
Факт начала ангины сам по себе говорит об ослаблении иммунитета и необходимости активировать иммунную защиту для борьбы с вирусами и бактериями. Поэтому в комплексной терапии тонзиллитов применяются средства для активации иммунитета. Например, Рафамин — препарат с единым противовирусным и антибактериальным действием – ускоряет формирование полноценного иммунного ответа против вирусов и против бактерий, а также позволяет усилить эффект антибиотиков.
Антибиотики при ангине назначаются только врачом после подтверждения бактериальной природы заболевания. Чаще всего доктор выписывает рецепт на антибактериальный препарат широкого спектра действия
При этом важно помнить, что в силу ряда причин даже точно подобранный антибиотик может не справиться с возбудителем инфекции, так как появилось очень много устойчивых к действию антибиотиков бактерий. Усилить антибактериальный эффект можно с помощью специально разработанных препаратов, таких как – Рафамин
При подозрении на ангину ни в коем случае нельзя заниматься самолечением: неправильный подбор или некорректная схема приема антибиотиков приведут к устойчивости бактерий и еще более ослабят иммунную систему. Поэтому людям, склонным к частым осложнениям после вирусных заболеваний и тем, у кого иммунитет изначально недостаточно силен, необходимо обязательно проконсультироваться с врачом.
Рафамин рекомендуется принимать и при первых признаках ОРВИ и гриппа, которые часто дополняются ангиной – чтобы помочь иммунной системе быстрее распознать и уничтожить любого возбудителя, как вирусной, так и бактериальной природы и не дать возможности развиться бактериальным осложнениям.
Кроме антибиотиков и средств активизации иммунитета для выздоровления потребуется и местное лечение. Чтобы убрать нагноение, нужно полоскать горло и орошать миндалины противомикробными средствами. При высокой температуре необходимы жаропонижающие и строгий постельный режим. При ангине следует много пить, например, теплый чай с корицей и медом.
Причины ангины
Порядка 80% случаев ангины связано с бактериальной инфекцией, в первую очередь – β-гемолитическим стрептококком группы А, Streptococcus pyogenes4. Реже заболевание вызывают другие виды стрептококков, стафилококки, пневмококки, менингококк, палочка инфлюэнцы, клебсиелла, микоплазмы, хламидии и вирусы (аденовирус).
Основными путями передачи ангины являются воздушно-капельный (через кашель, чихание) и алиментарный (съедение вместе с продуктами).
Риск развития тонзиллита повышается при переохлаждении, в том числе – потреблении холодных напитков или общем переохлаждении в холодное время года. Эти факторы снижают сопротивляемость тканей ротоглотки инфекционным агентам.
Реже встречаются ангины, развивающиеся как осложнение других заболеваний:
- Дифтерии,
- Кори,
- Скарлатины,
- Инфекционного мононуклеоза,
- Лейкозов,
- Агранулоциоза.
В чем отличие ангины и ОРВИ?
Острая респираторная вирусная инфекция (ОРВИ) вызывается различными вирусами, но не бактериями. Клинически ОРВИ протекает легче, чем ангина, в среднем проходя за 1 неделю даже без медикаментозного лечения. Также при ОРВИ редко наблюдается боль при глотании, а нарушение дыхания чаще обусловлено отеком слизистых оболочек носа, чем сужением ротоглотки. В свою очередь при ангине практически не возникает кашель и насморк.
Кто в группе риска?
На основе статистических данных и этиологии ангин можно выделить следующие категории населения, наиболее подверженные развитию тонзиллитов:
- Дети дошкольного и младшего школьного возраста.
- Люди, имеющее тесный контакт с другими, пребывающие в больших коллективах.
- Лица, отказавшиеся от плановой вакцинации против детских инфекционных заболеваний.
- Больные с нарушениями работы иммунной системы, приводящими к частым инфекционным заболеванием.
- Пациенты с сопутствующими гематологическими патологиями.
- Люди, страдающие от дефицита витаминов, или кахексии.
- Лица с искривлением носовой перегородки.
- Люди, страдающие от разрастания аденоидных вегетаций («аденоидов»).
- Больные с хроническими синуситами (фронтит, гайморит), ринитами, кариесом зубов.
В чем конкретные отличия ангины от ОРВИ?
Ключевое отличие недугов состоит в их возбудителе: в случае с ОРВИ эту роль играет вирус, в то время как ангина (острый тонзиллит) может быть вызвана и вирусом, и бактериями. Особенности симптоматики и течения заболеваний следующие:
Первое.
ОРВИ отличается размеренным течением: больной чувствует легкую утомляемость, страдает от слизистых носовых выделений, легкой боли в горле, кашля. При ангине симптомы проявляются резко: больной ощущает слабость и озноб, сильную боль в горле в момент глотания и суставную ломоту, наблюдается интоксикация организма.
Второе.
В случае с ангиной воспаление всегда охватывает ткань миндалин, которые набухают, краснеют, покрываются налетом и гнойными пробками. При ОРВИ миндалины не претерпевают существенных изменений, налет и гнойники на гландах отсутствуют. Воспалительный процесс может локализоваться в носовой полости, в горле или гортани.
Третье.
При остром тонзиллите температура тела больного высокая (от 38 градусов и выше). Она держится на протяжении всего периода развития недуга. При вирусной инфекции небольшая температура (до 38 градусов) может сохраниться первые 2-3 дня, затем спадает.
Четвертое.
Увеличение лимфатических узлов по направлению вниз от ушной мочки к крайнему челюстному углу – явный симптом ангины. Подобное обычно не наблюдается при ОРВИ.
Пятое.
В случае с острым тонзиллитом слизистые выделения из носа, заложенность и кашель обычно отсутствуют, болит только горло. Вирусная инфекция всегда развивается в сопровождении с кашлем и сильным насморком.
Шестое.
При ОРВИ неприятные симптомы достигают своего пика на третьи сутки, по истечении которых больной постепенно идет на поправку. Около 7-ми дней потребуется пациенту для полного выздоровления.
Для ангины, особенно если она пущена «на самотек», 3-4 день – самый разгар: увеличивается количество налета на миндалинах, появляется сильный жар, ухудшается общее самочувствие пациента. Лечебный процесс занимает до 2-х недель.
Седьмое.
Лечение ОРВИ может включать в себя применение исключительно народных методов. Если клиническая картина выражена неярко, это вполне оправдано.
Справиться с острым тонзиллитом поможет лишь комплексный подход, включающий прием антибактериальных средств, иногда возникает необходимость в хирургическом вмешательстве.
Восьмое.
Осложнения при ОРВИ, как и при обычной простуде, не угрожают жизни человека. Последствия запущенной ангины многочисленны. Некоторые из них могут привести к инвалидности или даже летальному исходу (абсцесс мозга, отек гортани и пр.).
Какие симптомы возникают при ангине
У тонзиллита имеется скрытый инкубационный период, составляющий около двух-трех дней. Болезнь начинается остро и проявляется следующей симптоматикой:
- воспаление лимфатических узлов на шее;
- лихорадка и озноб;
- боль в горле, отдающая в голову и уши;
- повышение температуры тела до 40С, при этом она может плохо и/или ненадолго сбиваться;
- мышечные и суставные боли;
- боль при глотательных движениях;
- головные боли.
На миндалинах могут образовываться гнойные участки. Ощущается слабое и разбитое состояние.
Также симптомы ангины зависят от ее вида:
- Катаральная. Для нее характерны симптомы общей интоксикации организма, незначительно повышается температура. Миндалины поражаются с двух сторон, они краснеют, на них может появиться налет. Заболевание длится в течение 5-7 дней.
- Фолликулярная. Миндалины краснеют, на них появляется налет желтого цвета и гнойные пробки. Может возникать рвота, диарея, лихорадка, температура поднимается до 39°С. Такая ангина длится более одной недели.
- Лакунарная. Для этой формы характерно сильное покраснение миндалин, появление налета серовато-желтого цвета, обширное образование гноя. Продолжительность заболевания составляет 7-14 дней.
- Фибринозная. Развивается на фоне вышеперечисленных форм заболевания или как их следствие. Признаки ангины данного вида такие же, но еще происходит образование пленки на миндалинах. Возможно течение заболевания с тяжелыми симптомами интоксикации организма и переход в менингит.
- Флегмонозная. При этой болезни сильно увеличивается одна миндалина, ее поверхность словно натягивается.
- Герпетическая. Вызывается вирусом герпеса. При такой ангине на миндалинах образуются пузырьки, краснеет и першит горло, поднимается температура. Продолжительность болезни составляет до пяти дней.
- Язвенно-пленочная. Сравнительно редкое заболевание, составляет около 5-6% всех ангин. Симптомы — появление на миндалинах язв, неприятного запаха из ротовой полости, чувства инородного тела в горле. Продолжительность заболевания составляет 7-21 день.
При гнойной ангине повышается температура тела, кружится голова, ощущается озноб, сильно болит горло. Иногда больного приходится госпитализировать. Горло при заболевании сильно краснеет, миндалины увеличиваются, происходит образование налета, участков гноя, фолликулов в зависимости от вида болезни.
Тонзиллит можно отличить от иных патологий по таким признакам:
- Коронавирусная инфекция — при тонзиллите отсутствуют такой симптом, как боль в грудной клетке, не развивается пневмония, клинические проявления исчезают за несколько дней. Для COVID-19 характерно затяжное течение болезни, необходимость длительного восстановления.
- ОРВИ. При ангине воспаление в основном ограничивается миндалинами. При острой респираторной вирусной инфекции не только болит горло, поднимается температура и увеличиваются лимфоузлы, но и возникает симптоматика, характерная для поражения верхних дыхательных путей. То есть ОРВИ отличается от ангины наличием таких состояний, как насморк, кашель, охриплость голоса.
- Грипп. При этом заболевании имеются и иные симптомы — при гриппе сильно ломит суставы, болит голова, появляется насморк. Основным симптомом тонзиллита является боль в горле, другие признаки менее выражены.
- Дифтерия. В отличие от ангины, при дифтерии горло болит несильно. Также заболевания отличаются тем, что у больного тонзиллитом спустя три-четыре дня наступают улучшения, у пациента с дифтерией — состояние ухудшается. Разница состоит и в том, что при дифтерии нельзя снять налет — на его месте появляется рана, вновь затягивающаяся пленка.
Чтобы точно определить диагноз, необходимо обратиться к специалисту и сдать назначенные им анализы.
Отличия ангины от фарингита
Фарингит — воспаление глотки, которое чаще всего носит вирусный характер, но изредка может быть и бактериальным. Как видно из определения, болезнь сильно отличается от ангины местом локализации воспаления, но основная проблема в том, что патологии могут протекать совместно (тонзиллофарингит). Если же имеет место изолированная форма того или иного воспалительного процесса, то отличие ангины от фарингита будет заключаться в следующем:
- Интоксикация при ангине всегда выражена сильнее, чем при банальном вирусном фарингите. Исключение составляет фарингит при гриппе, но последний довольно редко вызывает воспаление глотки в первые дни. Обычно при фарингите температура тела — до 37-38,5 градусов, во время ангины же она способна достигать 39-40 градусов.
- Фарингит, как правило, менее выражено сказывается на самочувствии больного: при гнойной ангине головная боль, ломота в теле, прочие признаки недомогания всегда сильнее.
- При остром тонзиллите боль в горле может быть значительнее с одной стороны, что особенно часто наблюдается при наличии хронической формы болезни. Фарингит же, напротив, равномерно охватывает всю глотку, небные дужки, а боль при нем не слишком выражена — превалируют першение, жжение, раздражение на задней стенке глотки. Во время фарингита болевой синдром и сухость могут сильнее проявляться по утрам, что обусловлено застоем слизи на глотке.
- Фарингит способен уже с первого дня дополняться сухим кашлем, который впоследствии становится влажным (начинает отделяться мокрота), а также насморком. Ангина вообще очень редко сопровождается такими симптомами, но иногда после присоединения осложнений тоже может проявляться кашлем, ринитом.
- Банальный фарингит обычно положительно реагирует на теплое питье: боль, першение быстро успокаиваются. Если же выпить горячий напиток во время острого тонзиллита, боль даст о себе знать еще сильнее.
Симптомы ангины
При ангинах инкубационный период составляет от 10 часов до 3 суток. Болезнь характеризуется острым началом, повышением температуры, ознобом, болями при глотании. Также наблюдается увеличение нижнечелюстных лимфоузлов. Как правило, увеличиваются те лимфоузлы, которые находятся ближе всего к источнику воспаления. Ведь именно лимфатическая система отвечает за захват и уничтожение чужеродных организмов.

1
Оториноларингология в МедикСити

2
Оториноларингология в МедикСити

3
Оториноларингология в МедикСити
Катаральная ангина отличается поверхностным поражением миндалин. Катаральная ангина может начаться внезапно, с температуры до 37,5 градусов. Заболевший ангиной чувствует недомогание, озноб, сильную головную боль и першение в горле, ему трудно глотать. Горло красное, миндалины рыхлые и увеличены в размере, на языке налет. При фарингоскопии наблюдается яркая разлитая гиперемия, отечность миндалин.
У пациента могут появиться небольшие изменения в крови и неярко выраженные признаки интоксикации. Симптомы держатся 1-2 дня, а затем исчезают. После этого болезнь может перейти в новую форму.
Лакунарная ангина – одна из распространенных форм катаральной ангины. При лакунарной ангине миндалины поражены в области лакун. Лакуны (углубления на поверхности миндалин) расширены, слизистая оболочка глотки и миндалин краснеет и отекает, миндалины покрываются гнойным налетом (который образуется из содержимого лакун). Налет удаляется легко, без кровоточащих следов.
Гнойная (фолликулярная) ангина лечится намного сложнее. Фолликулярная ангина отличается глубоким поражением миндалин. Слизистая оболочка миндалин воспалена, на ней видно множество беловато-желтоватых включений, похожих на зерна проса. Это нагноившиеся фолликулы, которые постепенно увеличиваются и лопаются с выделением гноя в полость глотки. Продолжительность болезни может быть до 10 дней.
Фолликулярную и лакунарную ангину сопровождает температура до 39-40 градусов. Пациенты жалуются на общую слабость, сильную боль при глотании, отдающую в ухо, головную боль, боли в сердце, мышцах и суставах. Голос становится неузнаваемым и хриплым. Лимфатические узлы на шее увеличиваются и становятся болезненными при прощупывании. Лабораторная диагностика выявляет лейкоцитоз, следы белка в крови, эритроциты в моче.
Некротическую ангину отличают от других форм более тяжелое течение и более выраженные симптомы. На миндалинах наблюдаются участки, покрытые налетом, распространяющимся вглубь слизистой оболочки. Налет имеет неровную изрытую поверхность зеленовато-желтого или серого цвета. При его удалении поверхность кровоточит, на тканях миндалин могут остаться глубокие дефекты. Нередко некрозы распространяются на заднюю стенку глотки и язычок.
Внимание! При ангине необходима консультация врача-отоларинголога! Наряду с перечисленными видами ангин существуют также атипичные ангины, которые требуют специфического лечения, нередко с госпитализацией
Диагностические мероприятия

Выявление вирусной ангины представляет определенные сложности. Необходимо обратиться к отоларингологу (ЛОР-врачу) для постановки точного диагноза.
На первичном приеме специалист опрашивает больного на предмет жалоб и их характера
Важно также провести сбор анамнеза, определить сопутствующие болезни, которые могли бы стать триггерными или иными факторами. Но этого мало
Далее показаны следующие манипуляции:
- Визуальная оценка зева с помощью зеркала и шпателя. Как правило, этого достаточно для постановки диагноза ангина, но далеко не для определения этиологии процесса.
- Мазок из зева для дальнейшего посева биоматериала на питательные среды. Позволяет обнаружить или исключить бактериальный генез патологии.
- ПЦР-диагностика. Требуется для выявления генетического материала вируса.
- ИФА-исследование. Направлено на определение характера процесса и его стадии (острый, хронический). Таким методом можно узнать давность заражения.
После постановки и верификации диагноза начинают лечение.
Нужно ли посещать врача
Каждый человек не раз сталкивался с головной болью, першением и болезненностью в горле. Поэтому многие люди не придают таким симптомам особого значения. В этом и заключается их огромная ошибка. Поскольку заболевания обладают схожими признаками, но требуют разного лечения. И при отсутствии своевременной медицинской помощи, могут провоцировать появление серьезных последствий.
Самостоятельно определить патологию трудно. Поэтому следует посетить врача, который назначит ряд диагностических исследований, помогающих в дифференцировании патологий. И на основании клинических данных, полученных жалоб пациента и субъективного обследования, назначит грамотную и эффективную терапию.



























